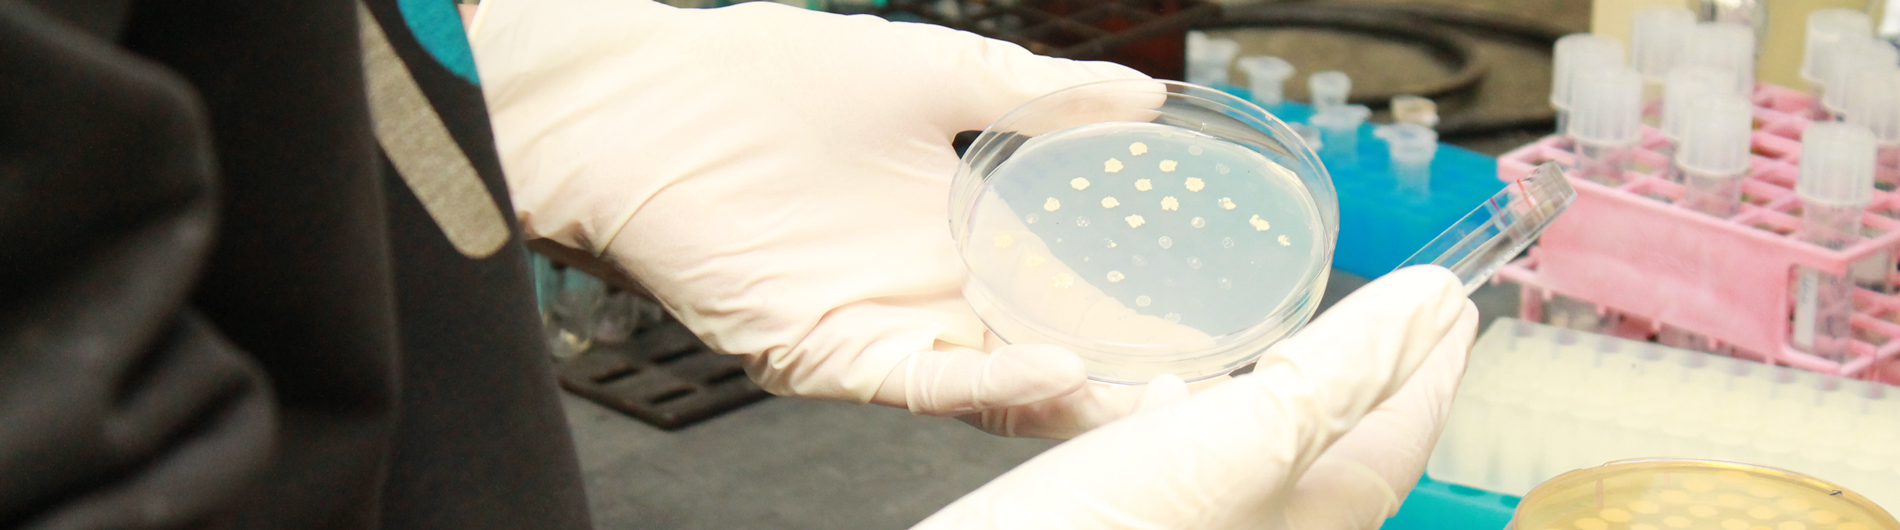
B&B Photo 6

Welcome to the Department of Biochemistry & Biophysics
 A Message from the Chair, Jeff Hayes, Ph.D.
A Message from the Chair, Jeff Hayes, Ph.D.
The Department of Biochemistry & Biophysics (B&B) strives to understand the molecular mechanisms of important biological processes, thereby providing insight into how disruption of these mechanisms causes disease. Departmental research is generously supported by the National Institutes of Health (NIH). The NIH also has recognized our excellence in the Biochemistry & Molecular Biology (BMB) and Biophysics, Structural & Computational Biology (BSCB) Ph.D. programs with a highly competitive interdepartmental T32 graduate training grant. Our commitment to graduate education is apparent from the positions acquired by our previous students and fellows, who are professors at major research universities and leaders in corporate research. Our continued focus is on pioneering research and quality education to ensure our position as a premier Biochemistry & Biophysics department.

Research
Our diverse faculty's cutting edge research spans several areas of biochemistry and biophysics.

Education
Our multiple programs prepare individuals for a career specifically focused on research and education in biochemistry and biophysics.

People
The Department of Biochemistry & Biophysics fosters collaborative research between laboratories and investigators.
Department Affiliated Centers & Facilities
Upcoming Events
“Linking Genome Structure with Function: A Journey of Histone Variant Discovery”
David Tremethick, BSc (Hons) (Syd), PhD (Macq)
Professor, Division of Genome Sciences and Cancer, Australian National University, College of Science and Medicine, Canberra, Australia
Tue, May 26 @ 1:00 PM
MC | Upper S-Wing Aud (3-7619)